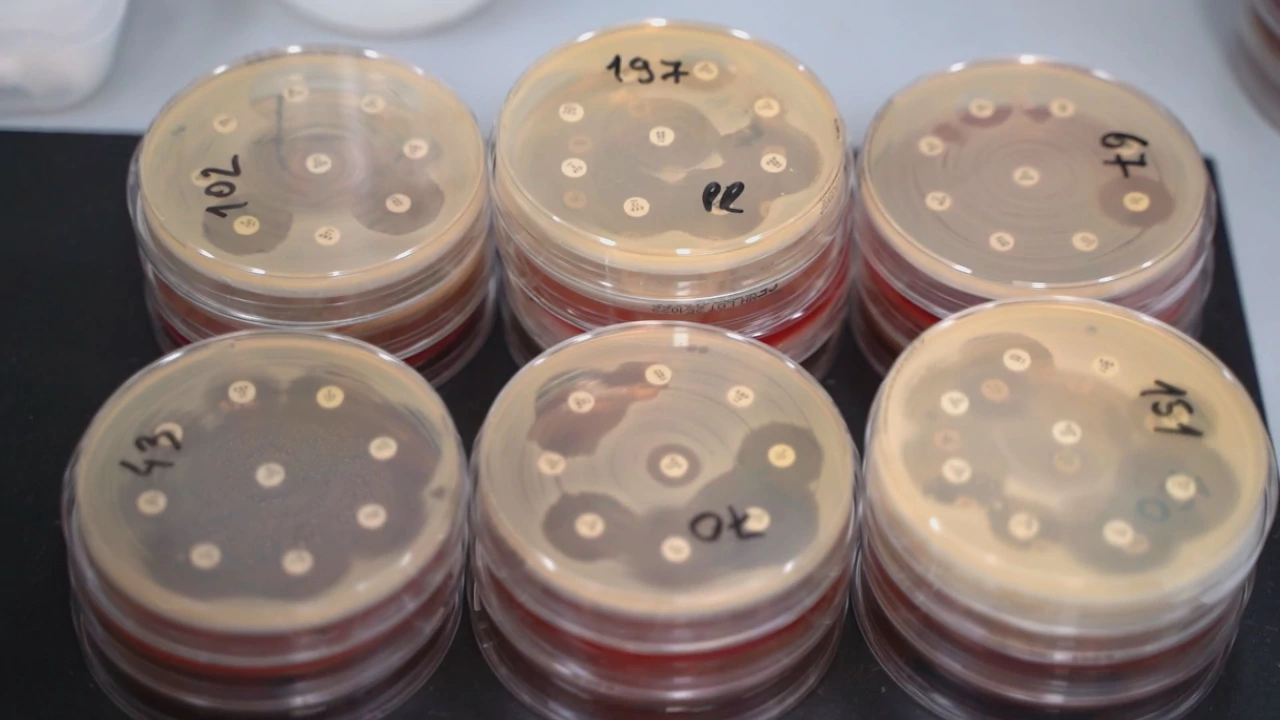
Četvrtak, 19. siječnja na Drugom, Foto: Zdrav život/HRT

Zdrav život je tjedna emisija koja informira o zdravlju, predstavlja rad naših vrsnih medicinskih stručnjaka, nudi korisne savjete i preporuke liječnika te razbija mitove i predrasude. Budite uz Drugi program četvrtkom u 18:45.
16.01.2023.
Zadnja izmjena 09:43
Autor: HRT
Zdrav život je tjedna emisija koja informira o zdravlju, predstavlja rad naših vrsnih medicinskih stručnjaka, nudi korisne savjete i preporuke liječnika te razbija mitove i predrasude. Budite uz Drugi program četvrtkom u 18:45.



U emisiji 19. siječnja u temi tjedna posjetili zagrebački Check point u kojem se može napraviti brzi test na AIDS.
Epidemiologinja Tatjana Nemeth Blažević otkrila kako je prošle godine u Hrvatskoj dijagnosticirano sto slučaja HIV pozitvnih.
U Profilu stručnjaka ugostili smo kardiologa Vjekoslava Radeljića koji nam je rekao nešto više o svom putu u medicinu, a posebno o novom načinu liječenja srčanih aritmija.
Posjetili smo i pogon za proizvodnju probiotika koji se danas nalaze i u vaginaletama i kremama, upoznali se s novim načinom liječenja ožiljaka koji su ne samo estetski, već i funkcionalni problem, a u Savjetu tjedna razgovarali smo s infektologom Rokom Čivljakom koji nas je upozorio na upalu pluća, u kontekstu najsmrtonosnije zarazne bolesti.

Autorica je Anja Alavanja Viljevac, izvršni producent Miroslav Rezić, a urednica Sanja Kocijančić Petričević.
Produkcija: Headline product d.o.o. za HRT, 2022.
Emisiju pogledajte i preko multimedijske platforme HRTi u čijoj su videoteci emitirana izdanja.
Vijesti HRT-a pratite na svojim pametnim telefonima i tabletima putem aplikacija za iOS i Android. Pratite nas i na društvenim mrežama Facebook, Twitter, Instagram, TikTok i YouTube!

Autorska prava - HRT © Hrvatska radiotelevizija.
Sva prava pridržana.
hrt.hr nije odgovoran za sadržaje eksternih izvora